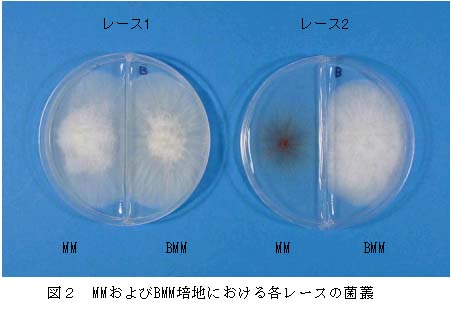

栄養要求性を利用したレタス根腐病菌のレース判別法
[要約]
クリスプヘッドレタスより分離したレタス根腐病菌Fusarium oxysporum f. sp.lactucaeのレースは栄養要求性の違いを利用して培地上で判別することが可能である。
| [キーワード] |
レタス根腐病、レース判別、栄養要求性 |
| [担当] |
長野県野菜花き試験場・病害虫部 |
| [連絡先] |
026-278-6848 |
| [区分] |
関東東海北陸農業・関東東海・病害虫、関東東海北陸農業・関東東海・総合研究 |
| [分類] |
技術・普及 |
[背景・ねらい]
クリスプヘッドレタス(以後レタス)根腐病は、長野県において被害面積が拡大しており総合防除対策の確立が急務となっている。県内産地のレタスから分離される病原菌(F. oxysporum f. sp. lactucae)には2つのレースが存在するが、接種試験による従来のレース判別は、多くの時間および労力を要する。本病菌のレース1とレース2では、レースに特異的な栄養要求性の差が認められることから、その性質を利用した簡便なレース判別法を開発し、抵抗性品種の効率的導入をはかる。
[成果の内容・特徴]
- 本病菌レース1の14菌株とレース2の21菌株について各種アミノ酸、ビタミン類を加用したMM培地における菌糸伸長、気中菌糸の有無を調査するとレース2はMM培地にビオチンを加用すると菌糸伸長が明らかに増加し、気中菌糸も豊富となり(データ略)、さらに胞子形成量が増加する(図1)。
- レース2の38菌株は、MM培地上で菌糸伸長が抑制され、気中菌糸もほとんど認められないが、培地へのビオチン加用によりすべて野生型菌叢となる。しかし、レース1の26菌株には菌糸に変化が認められず、ビオチン要求性はレース2に特異的である。
- レタス根腐病に罹病したレタス組織(維管束褐変部)から、常法により分離した菌株をMM培地およびビオチン加用MM培地(ビオチン500μg/L: 以後BMM培地)で25℃4~6日間培養する。菌糸生長がBMM培地と比較してMM培地で劣り、気中菌糸がほとんど認められないものをレース2、MM培地上での生育が良好なものをレース1と判定できる(図2)。
- 培地による判別結果と判別品種による接種試験の結果は一致することから、本法は分離菌株のレース判別に利用できる(表3)。
- MM培地の組成は以下の通りである。
Sucrose,30g; NaNO3,2g; KH2PO4,1g; MgSO4・7H2O,0.5g; KCl,0.5g; Trace elements
solution, 0.2mL; 寒天, 20g; 蒸留水 1L,(Trace elements solution:クエン酸,5g;
ZnSO4・7H2O, 5g; FeSO4・7H2O, 4.75g;
Fe(NH4)2(SO4)2・6H2O, 1g;
CuSO4・5H2O, 250mg; MnSO4・H2O, 50mg;
H3BO3,50mg; Na2MoO4・2H2O,50mg ;蒸留水,95mL)
[成果の活用面・留意点]
- 菌株は素寒天培地で分離後、単胞子分離することが望ましい。
- 保存菌株を用いるときは、できるだけ培地成分が混入しないようにする。
- 菌株は雑菌の混入を防ぐため、新鮮な組織から分離する。
[具体的データ]

[その他]
| 研究課題名 |
:植物抵抗性誘導技術を核としたレタス根腐病の総合防除 |
| 予算区分 |
:国補(地域基幹) |
| 研究期間 |
:1999~2001年度 |
| 研究担当者 |
:小木曽秀紀、藤永真史 |
目次へ戻る